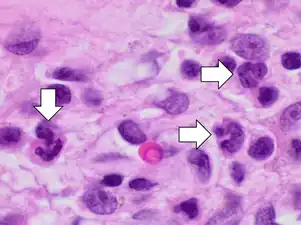
Acute inflammation characterized by neutrophils

Sinusitis
| Rhinosinusitis | |
|---|---|
| Other names | Sinus infection, sinusitis, chronic rhinosinusitis without nasal polyps, chronic rhinosinusitis with nasal polyps |
 | |
| An illustration showing the difference between healthy sinuses and diseased sinuses | |
| Specialty | Otorhinolaryngology |
| Symptoms | nasal discharge, nasal blockage, facial pain, reduction or loss of smell, fever[1][2] |
| Causes | Infection (bacterial, fungal, viral), allergies, air pollution, structural problems in the nose[3] |
| Risk factors | Asthma, cystic fibrosis, poor immune function[1] |
| Diagnostic method | Usually based on symptoms |
| Differential diagnosis | common cold, rhinitis, upper respiratory infection, temporomandibular joint disorder, tension headache, vascular headache, dental infection |
| Prevention | handwashing, vaccinations, avoiding smoking[3] |
| Treatment | Pain medications, nasal steroids, nasal irrigation, antibiotic[1][4] |
| Frequency | 10–30% each year (developed world)[1][5] |
Sinusitis, also known as rhinosinusitis, is an inflammation of the mucous membranes that line the sinuses resulting in symptoms that may include production of thick nasal mucus, nasal congestion, facial congestion, facial pain, facial pressure, loss of smell, or fever.[6][7]
Sinusitis is a condition that affects both children and adults. It is caused by a combination of environmental and a person's individual health factors.[8] It can occur in individuals with allergies, exposure to environmental irritants, structural abnormalities of the nasal cavity and sinuses and poor immune function.[9] Most cases are caused by a viral infection.[3] Recurrent episodes are more likely in persons with asthma, cystic fibrosis, and immunodeficiency.[10]
The diagnosis of sinusitis is based on the symptoms and their duration along with signs of disease identified by endoscopic and/or radiologic criteria.[11] Sinusitis is classified into acute sinusitis and chronic sinusitis. In acute sinusitis, symptoms last for less than 4 weeks. In chronic sinusitis symptoms must be present for at least 12 weeks.[12] In the initial evaluation of sinusitis an otolaryngologist, also known as an ear, nose and throat (ENT) doctor, may confirm sinusitis using nasal endoscopy.[11] Diagnostic imaging is not usually needed in acute stage unless complications are suspected.[13] In chronic cases, confirmatory testing is recommended by use of computed tomography.[13]
Prevention of sinusitis focuses on regular hand washing, staying up-to date on vaccinations, and avoiding smoking.[14] Pain killers such as naproxen, nasal steroids, and nasal irrigation may be used to help with symptoms.[15][16] Recommended initial treatment for acute sinusitis is watchful waiting.[15] If symptoms do not improve in 7–10 days or worsen, then an antibiotic may be implemented or changed.[15] In those in whom antibiotics are indicated, either amoxicillin or amoxicillin/clavulanate is recommended first line, with amoxicillin/clavulanate being superior to amoxicillin alone but with more side effects.[17][15] Surgery may be recommended in those with chronic disease who have failed medical management.[18]
Sinusitis is a common condition.[19] It affects between about 10 and 30 percent of people each year in the United States and Europe.[19][5] The management of sinusitis in the United States results in more than US$11 billion in costs.[19]
Signs and symptoms
Acute sinusitis can present as facial pain and tenderness that may worsen on standing up or bending over, headache, cough, bad breath, nasal congestion, ear pain, ear pressure or nasal discharge that is usually green in color, and may contain pus or blood.[20] Dental pain can also occur. A way to distinguish between toothache and sinusitis is that sinusitis-related pain is usually worsened by tilting the head forward or performing the Valsalva maneuver.[21]
Chronic sinusitis presents with more subtle symptoms of nasal obstruction, with less fever and pain complaints.[22] Symptoms include facial pain, headache, night-time coughing, an increase in previously minor or controlled asthma symptoms, general malaise, thick green or yellow nasal discharge, feeling of facial fullness or tightness that may worsen when bending over, dizziness, aching teeth, and bad breath.[23] Often, chronic sinusitis can lead to anosmia, the loss of the sense of smell.[23]
A 2005 review suggested that most "sinus headaches" are migraines.[24] The confusion occurs in part because migraine involves activation of the trigeminal nerves, which innervate both the sinus region and the meninges surrounding the brain. As a result, accurately determining the site from which the pain originates is difficult. People with migraines do not typically have the thick nasal discharge that is a common symptom of a sinus infection.[25]
By location
The four paired paranasal sinuses are the frontal, ethmoidal, maxillary, and sphenoidal sinuses. The ethmoidal sinuses are further subdivided into anterior and posterior ethmoid sinuses, the division of which is defined as the basal lamella of the middle nasal concha. In addition to the severity of disease, discussed below, sinusitis can be classified by the sinus cavity it affects:
- Maxillary – may cause pain or pressure in the maxillary (cheek) region, often experienced as toothache or headache.[26]
- Frontal – may cause pain or pressure in the frontal sinus cavity (above the eyes), often experienced as headache, particularly in the forehead area.
- Ethmoidal – may cause pain or pressure pain between or behind the eyes, along the sides of the upper nose (medial canthi), and headaches.[27]
- Sphenoidal – may cause pain or pressure behind the eyes, though it is often felt at top of the head, over the mastoid processes, or the back of the head.[27]
Complications
| Stage | Description |
|---|---|
| I | Preseptal cellulitis |
| II | Orbital cellulitis |
| III | Subperiosteal abscess |
| IV | Orbital abscess |
| V | Cavernous sinus septic thrombosis |
Complications are thought to be rare (1 case per 10,000).[28] Infectious complications of acute bacterial sinusitis include eye, brain and bone complications.[29]
Orbital complications
The Chandler Classification is used to group orbital complications into five stages according to their severity.[30] Stage I, known as preseptal cellulitis, occurs when an infection develops in front to the orbital septum.[31] It is thought to result from restricted venous drainage from the sinuses and affects the soft tissue of the eyelids and other superficial structures.[31] Stage II, known as orbital cellulitis, occurs when infection develops behind the orbital septum and affects the orbits.[31] This can result in impaired eye movement, protrusion of the eye, and eye swelling.[31] Stage III, known as subperiosteal abscess, occurs when pus collects between walls of the orbit and the surrounding periosteal structures.[31] This can result in impaired eye movement and acuity.[31] Stage IV, known as orbital abscess, occurs when an abscess forms within the orbital tissue.[31] This can result in severe vision impairment.[31] Stage V, known as cavernous sinus thrombosis, is considered an intracranial complication. It can occur as bacterial spread progresses, triggering blood clots that become trapped within the cavernous sinus.[32] This can result in previously described symptoms within the opposite eye and in severe cases, meningitis.[31]
Intracranial complications
The close proximity of the sinuses to the brain makes brain infections one of the most dangerous complication of acute bacterial sinusitis, especially when the frontal and sphenoid sinuses are involved. These infections can result from invasion of anaerobic bacteria through the bones or blood vessels. Abscesses, meningitis, and other life-threatening conditions may occur. In rare cases, mild personality changes, headache, altered consciousness, visual problems, seizures, coma, and even death may occur.[33]
Osseous complications
A rare complication of acute sinusitis is a bone infection, known as osteomyelitis, which affects the frontal and other facial bones.[34] Specifically, the combination of frontal sinusitis, osteomyelitis and subperiosteal abscess formation is referred to as Pott's puffy tumor.[35][34]
Other complications
When an infection originating from a tooth or dental procedure affects the maxillary sinus it can lead to odontogenic sinusitis (ODS).[36] Odontogenic sinusitis can often spread to nearby sinuses including the ethmoid, frontal, sphenoid sinuses, and the contralateral nasal cavity.[37] In rare instances, these infections may spread to the orbit, leading to orbital cellulitis.
Causes
Acute
Acute sinusitis is usually precipitated by an earlier upper respiratory tract infection, generally of viral origin, mostly caused by rhinoviruses (with RVA and RVC giving more severe infection than RVB), coronaviruses, and influenza viruses, others caused by adenoviruses, human parainfluenza viruses, human respiratory syncytial virus, enteroviruses other than rhinoviruses, and metapneumovirus. If the infection is of bacterial origin, the most common three causative agents are Streptococcus pneumoniae (38%), Haemophilus influenzae (36%), and Moraxella catarrhalis (16%).[38][39] Until recently, H. influenzae was the most common bacterial agent to cause sinus infections. However, introduction of the H. influenzae type B (Hib) vaccine has dramatically decreased these infections and now non-typable H. influenzae (NTHI) is predominantly seen in clinics. Other sinusitis-causing bacterial pathogens include S. aureus and other streptococci species, anaerobic bacteria and, less commonly, Gram-negative bacteria. Viral sinusitis typically lasts for 7 to 10 days.[28]
Acute episodes of sinusitis can also result from fungal invasion. These infections are typically seen in people with diabetes or other immune deficiencies (such as AIDS or transplant on immunosuppressive antirejection medications) and can be life-threatening. In type I diabetics, ketoacidosis can be associated with sinusitis due to mucormycosis.[40]
Chronic
Definition and nomenclature
By definition, chronic sinusitis lasts longer than 12 weeks and can be caused by many different diseases that share chronic inflammation of the sinuses as a common symptom. It is subdivided into cases with and without polyps. When polyps are present, the condition is called chronic hyperplastic sinusitis; however, the causes are poorly understood.[28] It may develop with anatomic derangements, including deviation of the nasal septum and the presence of concha bullosa (pneumatization of the middle concha) that inhibit the outflow of mucus, or with allergic rhinitis, asthma, cystic fibrosis, and dental infections.[41]
Chronic rhinosinusitis represents a multifactorial inflammatory disorder, rather than simply a persistent bacterial infection.[28] The medical management of chronic rhinosinusitis is now focused upon controlling the inflammation that predisposes people to obstruction, reducing the incidence of infections.[42] Surgery may be needed if medications are not working.[42]
Attempts have been made to provide a more consistent nomenclature for subtypes of chronic sinusitis. The presence of eosinophils in the mucous lining of the nose and paranasal sinuses has been demonstrated for many people, and this has been termed eosinophilic mucin rhinosinusitis (EMRS). Cases of EMRS may be related to an allergic response, but allergy is not often documented, resulting in further subcategorization into allergic and nonallergic EMRS.[43]
Fungi
A more recent, and still debated, development in chronic sinusitis is the role that fungi play in this disease.[44] Whether fungi are a definite factor in the development of chronic sinusitis remains unclear, and if they are, what is the difference between those who develop the disease and those who remain free of symptoms. Trials of antifungal treatments have had mixed results.[45]
One airway theory
Recent theories of sinusitis indicate that it often occurs as part of a spectrum of diseases that affect the respiratory tract (i.e., the "one airway" theory) and is often linked to asthma.[46][47]
Smoking
Both smoking and secondhand smoke are associated with chronic rhinosinusitis.[48]
Air pollution
Exposure to fine particulate matter (PM2.5), which consists of particles less than 2.5 micrometers in diameter, has been associated with an increased risk of developing rhinosinusitis.[49][50] PM2.5 particles can penetrate deep into the respiratory tract, reaching the nasal and sinus mucosa, leading to inflammation and impaired mucociliary clearance.[51] Individuals living in areas with higher concentrations of PM2.5 experience increased symptoms and exacerbations of chronic rhinosinusitis.[52] The fine particles cause oxidative stress and inflammation, contributing to the pathogenesis of rhinosinusitis.[53]
While both PM10 (particles less than 10 micrometers) and PM2.5 can affect the respiratory system, PM2.5 particles are more closely associated with rhinosinusitis due to their ability to reach deeper into the sinus cavities.[54] These smaller particles bypass the nasal hair filtering mechanism and deposit in the mucous membranes of the sinuses, leading to greater inflammatory responses.[55]
The World Health Organization (WHO) recommends that annual mean concentrations of PM2.5 should not exceed 5 μg/m3, and 24-hour mean exposures should not exceed 15 μg/m3 to minimize health risks.[56] Exposure to concentrations above these thresholds has been linked to an increased incidence and severity of rhinosinusitis and other respiratory diseases.[57]
Other diseases
Other diseases such as cystic fibrosis and granulomatosis with polyangiitis can also cause chronic sinusitis.[58]
Maxillary sinus
Maxillary sinusitis may also develop from problems with the teeth, and these cases were calculated to be about 40% in one study and 50% in another.[59] The cause of this situation is usually a periapical or periodontal infection of a maxillary posterior tooth, where the inflammatory exudate has eroded through the bone superiorly to drain into the maxillary sinus.[59]
An estimated 0.5 to 2.0% of viral rhinosinusitis (VRS) will develop into bacterial infections in adults and 5 to 10% in children.[38]
Pathophysiology
Chronic rhinosinusitis is multifactorial process hypothesized to be caused by inflammatory processes driven by dysfunction between local host and environmental interactions.[60] It is divided into two phenotypes that depend on the presence or absence of nasal polyps.[61] Chronic rhinosinusitis with nasal polyps and chronic rhinosinusitis without nasal polyps are thought to have two different inflammatory pathways, with the latter form driven by a Th1 response and the former driven by a Th2 response.[62] Both pathways result in an increase in inflammatory molecules (cytokines). The Th1 response is characterized by secretion of interferon gamma.[61] The Th2 response is characterized by secretion of interleukin-4 receptor, interleukin 5, and interleukin 13.[61] Both forms of chronic rhinosinusitis are considered to be highly heterogenous, each with the ability to demonstrate three inflammatory endotypes, the third being a Th17 response.[61]
Diagnosis
Classification

Sinusitis (or rhinosinusitis) is defined as an inflammation of the mucous membrane that lines the paranasal sinuses and is classified chronologically into several categories:[63]
- Acute sinusitis – A new infection that may last up to four weeks and can be subdivided symptomatically into severe and nonsevere. Some use definitions up to 12 weeks.[1]
- Recurrent acute sinusitis – Four or more full episodes of acute sinusitis that occur within one year
- Subacute sinusitis – An infection that lasts between four and 12 weeks, and represents a transition between acute and chronic infection.
- Chronic sinusitis – When the signs and symptoms last for more than 12 weeks.[1]
- Acute exacerbation of chronic sinusitis – When the signs and symptoms of chronic sinusitis exacerbate, but return to baseline after treatment.
Roughly 90% of adults have had sinusitis at some point in their lives.[64]
Acute
Health care providers distinguish bacterial and viral sinusitis by watchful waiting.[1] If a person has had sinusitis for fewer than 10 days without the symptoms becoming worse, then the infection is presumed to be viral.[1] When symptoms last more than 10 days or get worse in that time, then the infection is considered bacterial sinusitis.[65] Pain in the teeth and bad breath are also more indicative of bacterial disease.[66]
Imaging by either X-ray, CT or MRI is generally not recommended unless complications develop.[65] Pain caused by sinusitis is sometimes confused for pain caused by pulpitis (toothache) of the maxillary teeth, and vice versa. Classically, the increased pain when tilting the head forwards separates sinusitis from pulpitis.
For cases of maxillary sinusitis, limited field CBCT imaging, as compared to periapical radiographs, improves the ability to detect the teeth as the sources for sinusitis. A coronal CT picture may also be useful.[59]
Chronic
For sinusitis lasting more than 12 weeks, a CT scan is recommended.[65] On a CT scan, acute sinus secretions have a radiodensity of 10 to 25 Hounsfield units (HU), but in a more chronic state they become more viscous, with a radiodensity of 30 to 60 HU.[67]
Nasal endoscopy and clinical symptoms are also used to make a positive diagnosis.[28] A tissue sample for histology and cultures can also be collected and tested.[68] Nasal endoscopy involves inserting a flexible fiber-optic tube with a light and camera at its tip into the nose to examine the nasal passages and sinuses.
Sinus infections, if they result in tooth pain, usually present with pain involving more than one of the upper teeth, whereas a toothache usually involves a single tooth. Dental examination and appropriate radiography aid in ruling out pain arises from a tooth.[69]
.jpg) CT of chronic sinusitis
CT of chronic sinusitis CT scan of chronic sinusitis, showing a filled right maxillary sinus with sclerotic thickened bone
CT scan of chronic sinusitis, showing a filled right maxillary sinus with sclerotic thickened bone MRI image showing sinusitis. Edema and mucosal thickening appears in both maxillary sinuses.
MRI image showing sinusitis. Edema and mucosal thickening appears in both maxillary sinuses. Maxillary sinusitis caused by a dental infection associated with periorbital cellulitis
Maxillary sinusitis caused by a dental infection associated with periorbital cellulitis Frontal sinusitis
Frontal sinusitis X-ray of left-sided maxillary sinusitis marked by an arrow. There is lack of the air transparency indicating fluid in contrast to the other side.
X-ray of left-sided maxillary sinusitis marked by an arrow. There is lack of the air transparency indicating fluid in contrast to the other side.
Treatment
| Treatment | Indication | Rationale |
|---|---|---|
| Time | Viral and some bacterial sinusitis | Sinusitis is usually caused by a virus which is not affected by antibiotics.[70] |
| Antibiotics | Bacterial sinusitis | Cases accompanied by extreme pain, skin infection, or which last a long time may be caused by bacteria.[70] |
| Nasal irrigation | Nasal congestion | Can provide relief by helping decongest.[70] |
| Drink liquids | Thick phlegm | Remaining hydrated loosens mucus.[70] |
| Antihistamines | Concern with allergies | Antihistamines do not relieve typical sinusitis or cold symptoms much; this treatment is not needed in most cases.[70] |
| Nasal spray | Desire for temporary relief | Tentative evidence that it helps symptoms.[4] Does not treat cause. Not recommended for more than three days' use.[70] |
Recommended treatments for most cases of sinusitis include rest and drinking enough water to thin the mucus.[72] Antibiotics are not recommended for most cases.[72][73]
Breathing high-temperature steam such as from a hot shower or gargling can relieve symptoms.[72][74] There is tentative evidence for nasal irrigation in acute sinusitis, for example during upper respiratory infections.[4] Decongestant nasal sprays containing oxymetazoline may provide relief, but these medications should not be used for more than the recommended period. Longer use may cause rebound sinusitis.[75] It is unclear if nasal irrigation, antihistamines, or decongestants work in children with acute sinusitis.[76] There is no clear evidence that plant extracts such as Cyclamen europaeum are effective as an intranasal wash to treat acute sinusitis.[77] Evidence is inconclusive on whether anti-fungal treatments improve symptoms or quality of life.[78]
Antibiotics
Most sinusitis cases are caused by viruses and resolve without antibiotics.[28] However, if symptoms do not resolve within 10 days, either amoxicillin or amoxicillin/clavulanate are reasonable antibiotics for first treatment with amoxicillin/clavulanate being slightly superior to amoxicillin alone but with more side effects.[79][28] A 2018 Cochrane review, however, found no evidence that people with symptoms lasting seven days or more before consulting their physician are more likely to have bacterial sinusitis as one study found that about 80% of patients have symptoms lasting more than 7 days and another about 70%.[80] Antibiotics are specifically not recommended in those with mild / moderate disease during the first week of infection due to risk of adverse effects, antibiotic resistance, and cost.[81]
Fluoroquinolones, and a newer macrolide antibiotic such as clarithromycin or a tetracycline like doxycycline, are used in those who have severe allergies to penicillins.[82] Because of increasing resistance to amoxicillin the 2012 guideline of the Infectious Diseases Society of America recommends amoxicillin-clavulanate as the initial treatment of choice for bacterial sinusitis.[83] The guidelines also recommend against other commonly used antibiotics, including azithromycin, clarithromycin, and trimethoprim/sulfamethoxazole, because of growing antibiotic resistance. The FDA recommends against the use of fluoroquinolones when other options are available due to higher risks of serious side effects.[84]
A short-course (3–7 days) of antibiotics seems to be just as effective as the typical longer-course (10–14 days) of antibiotics for those with clinically diagnosed acute bacterial sinusitis without any other severe disease or complicating factors.[85] The IDSA guideline suggest five to seven days of antibiotics is long enough to treat a bacterial infection without encouraging resistance. The guidelines still recommend children receive antibiotic treatment for ten days to two weeks.[83]
Corticosteroids
For unconfirmed acute sinusitis, nasal sprays using corticosteroids have not been found to be better than a placebo either alone or in combination with antibiotics.[86] For cases confirmed by radiology or nasal endoscopy, treatment with intranasal corticosteroids alone or in combination with antibiotics is supported.[87] The benefit, however, is small.[88]
For confirmed chronic rhinosinusitis, there is limited evidence that intranasal steroids improve symptoms and insufficient evidence that one type of steroid is more effective.[89][90]
There is only limited evidence to support short treatment with corticosteroids by mouth for chronic rhinosinusitis with nasal polyps.[91][92][93] There is limited evidence to support corticosteroids by mouth in combination with antibiotics for acute sinusitis; it has only short-term effect improving the symptoms.[94][95]
Surgery
For sinusitis of dental origin, treatment focuses on removing the infection and preventing reinfection, by removal of the microorganisms, their byproducts, and pulpal debris from the infected root canal.[59] Systemic antibiotics are ineffective as a definitive solution, but may afford temporary relief of symptoms by improving sinus clearing, and may be appropriate for rapidly spreading infections, but debridement and disinfection of the root canal system at the same time is necessary. Treatment options include non-surgical root canal treatment, periradicular surgery, tooth replantation, or extraction of the infected tooth.[59]
For chronic or recurring sinusitis, referral to an otolaryngologist may be indicated, and treatment options may include nasal surgery. Surgery should only be considered for those people who do not benefit with medication or have non-invasive fungal sinusitis[96].[92][97] It is unclear how benefits of surgery compare to medical treatments in those with nasal polyps as this has been poorly studied.[98][99]
A number of surgical approaches can be used to access the sinuses and these have generally shifted from external/extranasal approaches to intranasal endoscopic ones. The benefit of functional endoscopic sinus surgery (FESS) is its ability to allow for a more targeted approach to the affected sinuses, reducing tissue disruption, and minimizing post-operative complications.[100] However, if a traditional FESS with Messerklinger technique is followed the success rate will be as low as 30%, 70% of the patients tend to have recurrence within 3 years.[101] On the other hand with use of TFSE technique along with navigation system, debriders and balloon sinuplasty or EBS can give a success rate of over 99.9%.[101] The use of drug eluting stents such as propel mometasone furoate implant may help in recovery after surgery.[102]
Another recently developed treatment is balloon sinuplasty. This method, similar to balloon angioplasty used to "unclog" arteries of the heart, utilizes balloons in an attempt to expand the openings of the sinuses in a less invasive manner.[42] The effectiveness of the functional endoscopic balloon dilation approach compared to conventional FESS is not known.[42]
Histopathology of sinonasal contents removed from surgery can be diagnostically valuable:
 Benign chronic mixed inflammation of an inflammatory sinonasal polyp
Benign chronic mixed inflammation of an inflammatory sinonasal polyp Acute inflammation characterized by neutrophils
Acute inflammation characterized by neutrophils Extranodal NK/T cell lymphoma, nasal type.[103] It may be incidentally discovered in people undergoing surgery for sinusitis.[104]
Extranodal NK/T cell lymphoma, nasal type.[103] It may be incidentally discovered in people undergoing surgery for sinusitis.[104]
Treatments directed to rhinovirus infection
A study has shown that patients given spray formulation of 0.73 mg of Tremacamra (a soluble intercellular adhesion molecule 1 [ICAM-1] receptor) reduced the severity of illness.[39]
Prognosis
A 2018 review has found that without the use of antibiotics, about 46% were cured after one week and 64% after two weeks.[80]
Epidemiology
Sinusitis is a common condition, with between 24 and 31 million cases occurring in the United States annually.[105][106] Chronic sinusitis affects approximately 12.5% of people.[48]
Research
Based on recent theories on the role that fungi may play in the development of chronic sinusitis, antifungal treatments have been used, on a trial basis. These trials have had mixed results.[28]
See also
References
- 1 2 3 4 5 6 7 8 Rosenfeld RM, Piccirillo JF, Chandrasekhar SS, Brook I, Kumar KA, Kramper M, et al. (April 2015). "Clinical practice guideline (update): Adult Sinusitis Executive Summary". Otolaryngology–Head and Neck Surgery. 152 (4): 598–609. doi:10.1177/0194599815574247. PMID 25833927. S2CID 206469424.
- ↑
- 1 2 3 "Sinus Infection (Sinusitis)". cdc.gov. September 30, 2013. Archived from the original on 7 April 2015. Retrieved 6 April 2015.
- 1 2 3 King D, Mitchell B, Williams CP, Spurling GK (April 2015). "Saline nasal irrigation for acute upper respiratory tract infections" (PDF). The Cochrane Database of Systematic Reviews. 2015 (4): CD006821. doi:10.1002/14651858.CD006821.pub3. PMC 9475221. PMID 25892369. Archived (PDF) from the original on 2021-08-29. Retrieved 2018-04-20.
- 1 2 Adkinson NF (2014). Middleton's allergy: principles and practice (Eight ed.). Philadelphia: Elsevier Saunders. p. 687. ISBN 9780323085939. Archived from the original on 2016-06-03.
- ↑ Rosenfeld RM, Piccirillo JF, Chandrasekhar SS, Brook I, Kumar KA, Kramper M, et al. (April 2015). "Clinical practice guideline (update): Adult Sinusitis Executive Summary". Otolaryngology–Head and Neck Surgery. 152 (4): 598–609. doi:10.1177/0194599815574247. PMID 25833927. S2CID 206469424.
- ↑ Head K, Chong LY, Piromchai P, Hopkins C, Philpott C, Schilder AG, et al. (April 2016). "Systemic and topical antibiotics for chronic rhinosinusitis" (PDF). The Cochrane Database of Systematic Reviews. 2016 (4): CD011994. doi:10.1002/14651858.CD011994.pub2. PMC 8763400. PMID 27113482. S2CID 205210696. Archived (PDF) from the original on 2018-07-22. Retrieved 2019-09-17.
- ↑ Battisti AS, Modi P, Pangia J (2024), "Sinusitis", StatPearls, Treasure Island (FL): StatPearls Publishing, PMID 29262090, archived from the original on 2023-11-18, retrieved 2024-11-12
- ↑ Adkinson NF (2014). Middleton's allergy: principles and practice (Eight ed.). Philadelphia: Elsevier Saunders. p. 687. ISBN 9780323085939. Archived from the original on 2016-06-03.
- ↑ Rosenfeld RM, Piccirillo JF, Chandrasekhar SS, Brook I, Kumar KA, Kramper M, et al. (April 2015). "Clinical practice guideline (update): Adult Sinusitis Executive Summary". Otolaryngology–Head and Neck Surgery. 152 (4): 598–609. doi:10.1177/0194599815574247. PMID 25833927. S2CID 206469424.
- 1 2 Adkinson NF (2014). Middleton's allergy: principles and practice (Eight ed.). Philadelphia: Elsevier Saunders. p. 687. ISBN 9780323085939. Archived from the original on 2016-06-03.
- ↑ Adkinson NF, Middleton E, eds. (2014). Middleton's allergy: principles and practice (8th ed.). Philadelphia, PA: Elsevier/Saunders. ISBN 978-0-323-08593-9.
- 1 2 Rosenfeld RM, Piccirillo JF, Chandrasekhar SS, Brook I, Kumar KA, Kramper M, et al. (April 2015). "Clinical practice guideline (update): Adult Sinusitis Executive Summary". Otolaryngology–Head and Neck Surgery. 152 (4): 598–609. doi:10.1177/0194599815574247. PMID 25833927. S2CID 206469424.
- ↑ "Sinus Infection (Sinusitis)". cdc.gov. September 30, 2013. Archived from the original on 7 April 2015. Retrieved 6 April 2015.
- 1 2 3 4 Rosenfeld RM, Piccirillo JF, Chandrasekhar SS, Brook I, Kumar KA, Kramper M, et al. (April 2015). "Clinical practice guideline (update): Adult Sinusitis Executive Summary". Otolaryngology–Head and Neck Surgery. 152 (4): 598–609. doi:10.1177/0194599815574247. PMID 25833927. S2CID 206469424.
- ↑ King D, Mitchell B, Williams CP, Spurling GK (April 2015). "Saline nasal irrigation for acute upper respiratory tract infections" (PDF). The Cochrane Database of Systematic Reviews. 2015 (4): CD006821. doi:10.1002/14651858.CD006821.pub3. PMC 9475221. PMID 25892369. Archived (PDF) from the original on 2021-08-29. Retrieved 2018-04-20.
- ↑ Orlandi RR, Kingdom TT, Smith TL, Bleier B, DeConde A, Luong AU, et al. (2021). "International consensus statement on allergy and rhinology: rhinosinusitis 2021" (PDF). International Forum of Allergy & Rhinology. 11 (3). Wiley: 213–739. doi:10.1002/alr.22741. ISSN 2042-6976. PMID 33236525. S2CID 227165628. Archived (PDF) from the original on 2023-03-07. Retrieved 2023-01-21.
- ↑ "How Is Sinusitis Treated". April 3, 2012. Archived from the original on 5 April 2015. Retrieved 6 April 2015.
- 1 2 3 Rosenfeld RM, Piccirillo JF, Chandrasekhar SS, Brook I, Kumar KA, Kramper M, et al. (April 2015). "Clinical practice guideline (update): Adult Sinusitis Executive Summary". Otolaryngology–Head and Neck Surgery. 152 (4): 598–609. doi:10.1177/0194599815574247. PMID 25833927. S2CID 206469424.
- ↑ "Sinusitis". herb2000.com. Archived from the original on 2011-05-25.
Incidence of acute sinusitis almost always set in following the appearance of a cold for several days at a stretch in the person to the point that all the profuse nasal discharge turns a distinct yellow or a dark green color, or perhaps very thick, and foul-smelling in some cases.
- ↑ Ferguson M (September 2014). "Rhinosinusitis in oral medicine and dentistry". Australian Dental Journal. 59 (3): 289–95. doi:10.1111/adj.12193. PMID 24861778.
- ↑ Pasha R (2013). Otolaryngology-Head and Neck Surgery: Clinical Reference Guide (4th ed.). Plural Publishing Inc. ISBN 978-1597565325.
- 1 2 Radojicic C. "Sinusitis". Disease Management Project. Cleveland Clinic. Archived from the original on November 14, 2012. Retrieved November 26, 2012.
- ↑ Mehle ME, Schreiber CP (October 2005). "Sinus headache, migraine, and the otolaryngologist". Otolaryngology–Head and Neck Surgery. 133 (4): 489–96. doi:10.1016/j.otohns.2005.05.659. PMID 16213917. S2CID 40427174.
- ↑ Headache Classification Subcommittee of the International Headache Society (2004). "The International Classification of Headache Disorders: 2nd edition". Cephalalgia. 24 (Suppl 1): 9–160. doi:10.1111/j.1468-2982.2004.00653.x. PMID 14979299.
- ↑ Ferguson M (September 2014). "Rhinosinusitis in oral medicine and dentistry". Australian Dental Journal. 59 (3): 289–95. doi:10.1111/adj.12193. PMID 24861778.
- 1 2 Terézhalmy GT, Huber MA, Jones AC, Noujeim M, Sankar V (2009). Physical evaluation in dental practice. Ames, Iowa: Wiley-Blackwell. p. 27. ISBN 978-0-8138-2131-3.
- 1 2 3 4 5 6 7 8 Leung RS, Katial R (March 2008). "The diagnosis and management of acute and chronic sinusitis". Primary Care. 35 (1): 11–24, v–vi. doi:10.1016/j.pop.2007.09.002. PMID 18206715.
- ↑ Scholes MA, Ramakrishnan VR (May 9, 2022). ENT secrets (5th ed.). Elsevier Health Sciences. pp. 155–160. ISBN 9780323733588.
- ↑ Chandler JR, Langenbrunner DJ, Stevens ER (September 1970). "The pathogenesis of orbital complications in acute sinusitis". The Laryngoscope. 80 (9): 1414–28. doi:10.1288/00005537-197009000-00007. PMID 5470225. S2CID 32773653.
- 1 2 3 4 5 6 7 8 9 Bae C, Bourget D (2024), "Periorbital Cellulitis", StatPearls, Treasure Island (FL): StatPearls Publishing, PMID 29261970, retrieved 2024-11-13
- ↑ Plewa MC, Tadi P, Gupta M (2024), "Cavernous Sinus Thrombosis", StatPearls, Treasure Island (FL): StatPearls Publishing, PMID 28846357, retrieved 2024-11-13
- ↑ "Sinusitus Complications". Patient Education. University of Maryland. Archived from the original on 2010-02-22.
- 1 2 Wadhwa S, Jain S, Gupta J, Dobariya H, Pantbalekundri N, Wadhwa S, et al. (2024-02-13). "Osteomyelitis of Frontal Sinus: A Rare Sequelae of Acute Bacterial Sinusitis Associated With Anatomical Variations in the Frontal Sinus Drainage Pathway". Cureus. 16 (2): e54158. doi:10.7759/cureus.54158. ISSN 2168-8184. PMC 10940872. PMID 38496067.
- ↑ "Sinusitus Complications". Patient Education. University of Maryland. Archived from the original on 2010-02-22.
- ↑ Craig JR, Poetker DM, Aksoy U, Allevi F, Biglioli F, Cha BY, et al. (2021-02-14). "Diagnosing odontogenic sinusitis: An international multidisciplinary consensus statement". International Forum of Allergy & Rhinology. 11 (8): 1235–1248. doi:10.1002/alr.22777. hdl:2027.42/168522. ISSN 2042-6976. PMID 33583151.
- ↑ Saibene AM, Pipolo GC, Lozza P, Maccari A, Portaleone SM, Scotti A, et al. (December 2014). "Redefining boundaries in odontogenic sinusitis: a retrospective evaluation of extramaxillary involvement in 315 patients: Odontogenic sinusitis extramaxillary involvement". International Forum of Allergy & Rhinology. 4 (12): 1020–1023. doi:10.1002/alr.21400. PMID 25196643. S2CID 28835025. Archived from the original on 2024-02-25. Retrieved 2021-03-27.
- 1 2 DeBoer DL, Kwon E (2020). "Acute Sinusitis". Statpearls. PMID 31613481.
 Text was copied from this source, which is available under a Creative Commons Attribution 4.0 International License "Deed - Attribution 4.0 International - Creative Commons". Archived from the original on 2017-10-16. Retrieved 2020-11-27.
Text was copied from this source, which is available under a Creative Commons Attribution 4.0 International License "Deed - Attribution 4.0 International - Creative Commons". Archived from the original on 2017-10-16. Retrieved 2020-11-27.{{cite web}}: CS1 maint: bot: original URL status unknown (link). - 1 2 Basharat U, Aiche MM, Kim MM, Sohal M, Chang EH (October 2019). "Are rhinoviruses implicated in the pathogenesis of sinusitis and chronic rhinosinusitis exacerbations? A comprehensive review". Int Forum Allergy Rhinol. 9 (10): 1159–1188. doi:10.1002/alr.22403. PMID 31430424. S2CID 201117207.
- ↑ Mucormycosis at eMedicine
- ↑ White SC, Pharoah MJ (12 September 2018). Oral radiology: principles and interpretation. St. Louis, Missouri: Elsevier. ISBN 9780323543842.
- 1 2 3 4 Ahmed J, Pal S, Hopkins C, Jayaraj S (July 2011). "Functional endoscopic balloon dilation of sinus ostia for chronic rhinosinusitis". The Cochrane Database of Systematic Reviews (7): CD008515. doi:10.1002/14651858.CD008515.pub2. PMID 21735433.
- ↑ Chakrabarti A, Denning DW, Ferguson BJ, Ponikau J, Buzina W, Kita H, et al. (September 2009). "Fungal rhinosinusitis: a categorization and definitional schema addressing current controversies". The Laryngoscope. 119 (9): 1809–18. doi:10.1002/lary.20520. PMC 2741302. PMID 19544383.
- ↑ Boodman SG (1999-11-23). "Mayo Report on Sinusitis Draws Skeptics". The Washington Post. Archived from the original on 2019-03-06. Retrieved 2018-06-01.
- ↑ Rank MA, Adolphson CR, Kita H (February 2009). "Antifungal therapy for chronic rhinosinusitis: the controversy persists". Current Opinion in Allergy and Clinical Immunology. 9 (1): 67–72. doi:10.1097/ACI.0b013e328320d279. PMC 3914414. PMID 19532095.
- ↑ Grossman J (February 1997). "One airway, one disease". Chest. 111 (2 Suppl): 11S – 16S. doi:10.1378/chest.111.2_Supplement.11S. PMID 9042022.
- ↑ Cruz AA (July 2005). "The 'united airways' require an holistic approach to management". Allergy. 60 (7): 871–4. doi:10.1111/j.1398-9995.2005.00858.x. PMID 15932375. S2CID 7490538.
- 1 2 Hamilos DL (October 2011). "Chronic rhinosinusitis: epidemiology and medical management". The Journal of Allergy and Clinical Immunology. 128 (4): 693–707, quiz 708–9. doi:10.1016/j.jaci.2011.08.004. PMID 21890184.
- ↑ Kim H (2015). "Effects of Particulate Matter (PM2.5) on Nasal Mucociliary Transport and Mucus Secretion in Human Nasal Epithelial Cells". American Journal of Rhinology & Allergy. 29 (6): 383–386. doi:10.2500/ajra.2015.29.4236. PMID 26634607.
- ↑ Hwang S (2020). "Long-term exposure to ambient air pollutants and chronic rhinosinusitis in adulthood". International Forum of Allergy & Rhinology. 10 (6): 748–756. doi:10.1002/alr.22520. PMID 32129401.
- ↑ Reh DD (2012). "Environmental exposures and chronic rhinosinusitis: a systematic review". Otolaryngology–Head and Neck Surgery. 146 (5): 733–741. doi:10.1016/j.jhsa.2012.01.003. PMID 22386545.
- ↑ Zhang Z (2014). "Association between indoor air pollution and chronic rhinosinusitis: a systematic review". International Forum of Allergy & Rhinology. 4 (1): 4–15. doi:10.1002/alr.21254. PMID 24122709.
- ↑ Harvey RJ (2015). "Mucosal inflammation in chronic rhinosinusitis: response to medical treatment". Current Opinion in Otolaryngology & Head and Neck Surgery. 23 (1): 1–6. doi:10.1097/MOO.0000000000000122. PMID 25490611. Archived from the original on 2024-04-28. Retrieved 2024-11-23.
- ↑ Maniscalco M (2015). "High atmospheric particulate matter (PM2.5) exposure is associated with increased nasal inflammation in allergic rhinitis". Rhinology. 53 (3): 193–199. doi:10.3950/jibiinkoka.118.213. PMID 26349337.
- ↑ D'Amato G (2018). "Climate change, air pollution, and allergic respiratory diseases: a call to action for health professionals". Multidisciplinary Respiratory Medicine. 13 (9 Suppl): S8 – S41. doi:10.1186/s40248-018-0122-7 (inactive 2024-11-23). PMC 5788261. PMID 29410723.
{{cite journal}}: CS1 maint: DOI inactive as of November 2024 (link) - ↑ WHO global air quality guidelines: Particulate matter (PM2.5 and PM10), ozone, nitrogen dioxide, sulfur dioxide and carbon monoxide. World Health Organization. 22 September 2021. ISBN 9789240034228. Retrieved 23 November 2024.
- ↑ Peden DB (2020). "Mechanisms of pollution-induced airway disease: in vivo studies". Allergy, Asthma & Clinical Immunology. 16 (1): 680–681. doi:10.1186/s13223-020-00431-3. PMC 7387257. PMID 32393680.
- ↑ Marks SC, Kissner DG (1997). "Management of sinusitis in adult cystic fibrosis". American Journal of Rhinology. 11 (1): 11–4. doi:10.2500/105065897781446810. PMID 9065342. S2CID 5606258.
- 1 2 3 4 5 "Maxillary Sinusitis of Endodontic Origin" (PDF). American Association of Endodontists. 2018. Archived (PDF) from the original on 26 March 2019. Retrieved 26 March 2019.
- ↑ Fokkens W, Lund V, Hopkins C, Hellings P, Kern R, Reitsma S, et al. (2020-02-01). "European Position Paper on Rhinosinusitis and Nasal Polyps 2020" (PDF). Rhinology Journal. 58 (Suppl S29): 1–464. doi:10.4193/Rhin20.600. PMID 32077450.
- 1 2 3 4 Kato A, Schleimer RP, Bleier BS (May 2022). "Mechanisms and pathogenesis of chronic rhinosinusitis". Journal of Allergy and Clinical Immunology. 149 (5): 1491–1503. doi:10.1016/j.jaci.2022.02.016. ISSN 0091-6749. PMC 9081253. PMID 35245537.
- ↑ Scholes MA, Ramakrishnan VR (May 9, 2022). ENT secrets (5th ed.). Elsevier Health Sciences. pp. 155–160. ISBN 9780323733588.
- ↑ Radojicic C. "Sinusitis". Disease Management Project. Cleveland Clinic. Archived from the original on November 14, 2012. Retrieved November 26, 2012.
- ↑ Pearlman AN, Conley DB (June 2008). "Review of current guidelines related to the diagnosis and treatment of rhinosinusitis". Current Opinion in Otolaryngology & Head and Neck Surgery. 16 (3): 226–30. doi:10.1097/MOO.0b013e3282fdcc9a. PMID 18475076. S2CID 23638755.
- 1 2 3 Rosenfeld RM, Andes D, Bhattacharyya N, Cheung D, Eisenberg S, Ganiats TG, et al. (September 2007). "Clinical practice guideline: adult sinusitis". Otolaryngology–Head and Neck Surgery. 137 (3 Suppl): S1-31. doi:10.1016/j.otohns.2007.06.726. PMID 17761281. S2CID 16593182.
- ↑ Ebell MH, McKay B, Dale A, Guilbault R, Ermias Y (March 2019). "Accuracy of Signs and Symptoms for the Diagnosis of Acute Rhinosinusitis and Acute Bacterial Rhinosinusitis". Annals of Family Medicine. 17 (2): 164–172. doi:10.1370/afm.2354. PMC 6411403. PMID 30858261.
- ↑ Page 674 Archived 2017-02-16 at the Wayback Machine in: Flint PW, Haughey BH, Niparko JK, Richardson MA, Lund VJ, Robbins KT, et al. (2010). Cummings Otolaryngology – Head and Neck Surgery, 3-Volume Set. Elsevier Health Sciences. ISBN 9780323080873.
- ↑ Harrison's Manual of Medicine 16/e
- ↑ Glick M (30 June 2014). Burket's oral medicine (12th ed.). Shelton, Connecticut: Burket's oral medicine. p. 341. ISBN 978-1-60795-280-0. OCLC 903962852.
- 1 2 3 4 5 6 7 Consumer Reports, American Academy of Family Physicians (April 2012). "Treating sinusitis: Don't rush to antibiotics" (PDF). Choosing wisely: an initiative of the ABIM Foundation. Consumer Reports. Archived (PDF) from the original on June 11, 2012. Retrieved August 17, 2012.
- ↑ American Academy of Allergy, Asthma, and Immunology. "Five things physicians and patients should question" (PDF). Choosing Wisely: an initiative of the ABIM Foundation. American Academy of Allergy, Asthma, and Immunology. Archived (PDF) from the original on November 3, 2012. Retrieved August 14, 2012.
- 1 2 3 Consumer Reports, American Academy of Allergy, Asthma, and Immunology (July 2012), "Treating sinusitis: Don't rush to antibiotics" (PDF), Choosing Wisely: an initiative of the ABIM Foundation, Consumer Reports, archived (PDF) from the original on January 24, 2013, retrieved August 14, 2012
- ↑ Lemiengre MB, van Driel ML, Merenstein D, Liira H, Mäkelä M, De Sutter AI (September 2018). "Antibiotics for acute rhinosinusitis in adults". The Cochrane Database of Systematic Reviews. 2018 (9): CD006089. doi:10.1002/14651858.CD006089.pub5. PMC 6513448. PMID 30198548.
- ↑ Harvey R, Hannan SA, Badia L, Scadding G (July 2007). Harvey R (ed.). "Nasal saline irrigations for the symptoms of chronic rhinosinusitis". The Cochrane Database of Systematic Reviews (3): CD006394. doi:10.1002/14651858.CD006394.pub2. PMID 17636843.
- ↑ Rhinitis medicamentosa at eMedicine
- ↑ Shaikh N, Wald ER (October 2014). "Decongestants, antihistamines and nasal irrigation for acute sinusitis in children". The Cochrane Database of Systematic Reviews. 2014 (10): CD007909. doi:10.1002/14651858.CD007909.pub4. PMC 7182143. PMID 25347280.
- ↑ Zalmanovici Trestioreanu A, Barua A, Pertzov B (May 2018). "Cyclamen europaeum extract for acute sinusitis". The Cochrane Database of Systematic Reviews. 5 (8): CD011341. doi:10.1002/14651858.CD011341.pub2. PMC 6494494. PMID 29750825.
- ↑ Head K, Sharp S, Chong LY, Hopkins C, Philpott C (September 2018). "Topical and systemic antifungal therapy for chronic rhinosinusitis". The Cochrane Database of Systematic Reviews. 2018 (9): CD012453. doi:10.1002/14651858.cd012453.pub2. PMC 6513454. PMID 30199594.
- ↑ Orlandi RR, Kingdom TT, Smith TL, Bleier B, DeConde A, Luong AU, et al. (2021). "International consensus statement on allergy and rhinology: rhinosinusitis 2021" (PDF). International Forum of Allergy & Rhinology. 11 (3). Wiley: 213–739. doi:10.1002/alr.22741. ISSN 2042-6976. PMID 33236525. S2CID 227165628. Archived (PDF) from the original on 2023-03-07. Retrieved 2023-01-21.
- 1 2 Lemiengre MB, van Driel ML, Merenstein D, Liira H, Mäkelä M, De Sutter AI (September 2018). "Antibiotics for acute rhinosinusitis in adults". Cochrane Database Syst Rev. 2018 (9): CD006089. doi:10.1002/14651858.CD006089.pub5. PMC 6513448. PMID 30198548.
- ↑ Smith SR, Montgomery LG, Williams JW (March 2012). "Treatment of mild to moderate sinusitis". Archives of Internal Medicine. 172 (6): 510–3. doi:10.1001/archinternmed.2012.253. PMID 22450938.
- ↑ Karageorgopoulos DE, Giannopoulou KP, Grammatikos AP, Dimopoulos G, Falagas ME (March 2008). "Fluoroquinolones compared with beta-lactam antibiotics for the treatment of acute bacterial sinusitis: a meta-analysis of randomized controlled trials". CMAJ. 178 (7): 845–54. doi:10.1503/cmaj.071157. PMC 2267830. PMID 18362380.
- 1 2 Chow AW, Benninger MS, Brook I, Brozek JL, Goldstein EJ, Hicks LA, et al. (April 2012). "IDSA clinical practice guideline for acute bacterial rhinosinusitis in children and adults". Clinical Infectious Diseases. 54 (8): e72 – e112. doi:10.1093/cid/cir1043. PMID 22438350.
- ↑ "Fluoroquinolone Antibacterial Drugs: Drug Safety Communication – FDA Advises Restricting Use for Certain Uncomplicated Infections". FDA. 12 May 2016. Archived from the original on 16 May 2016. Retrieved 16 May 2016.
- ↑ Falagas ME, Karageorgopoulos DE, Grammatikos AP, Matthaiou DK (February 2009). "Effectiveness and safety of short vs. long duration of antibiotic therapy for acute bacterial sinusitis: a meta-analysis of randomized trials". British Journal of Clinical Pharmacology. 67 (2): 161–71. doi:10.1111/j.1365-2125.2008.03306.x. PMC 2670373. PMID 19154447.
- ↑ Williamson IG, Rumsby K, Benge S, Moore M, Smith PW, Cross M, et al. (December 2007). "Antibiotics and topical nasal steroid for treatment of acute maxillary sinusitis: a randomized controlled trial". JAMA. 298 (21): 2487–96. doi:10.1001/jama.298.21.2487. PMID 18056902.
- ↑ Zalmanovici Trestioreanu A, Yaphe J (December 2013). "Intranasal steroids for acute sinusitis". The Cochrane Database of Systematic Reviews. 12 (12): CD005149. doi:10.1002/14651858.CD005149.pub4. PMC 6698484. PMID 24293353.
- ↑ Hayward G, Heneghan C, Perera R, Thompson M (2012). "Intranasal corticosteroids in management of acute sinusitis: a systematic review and meta-analysis". Annals of Family Medicine. 10 (3): 241–9. doi:10.1370/afm.1338. PMC 3354974. PMID 22585889.
- ↑ Chong LY, Head K, Hopkins C, Philpott C, Schilder AG, Burton MJ (April 2016). "Intranasal steroids versus placebo or no intervention for chronic rhinosinusitis". The Cochrane Database of Systematic Reviews. 2016 (4): CD011996. doi:10.1002/14651858.cd011996.pub2. PMC 9393647. PMID 27115217. S2CID 205210710. Archived from the original on 2019-11-15. Retrieved 2019-11-15.
- ↑ Chong LY, Head K, Hopkins C, Philpott C, Burton MJ, Schilder AG (April 2016). "Different types of intranasal steroids for chronic rhinosinusitis". The Cochrane Database of Systematic Reviews. 2016 (4): CD011993. doi:10.1002/14651858.cd011993.pub2. PMC 8939045. PMID 27115215. S2CID 205210689.
- ↑ Head K, Chong LY, Hopkins C, Philpott C, Burton MJ, Schilder AG (April 2016). "Short-course oral steroids alone for chronic rhinosinusitis". The Cochrane Database of Systematic Reviews. 2016 (4): CD011991. doi:10.1002/14651858.cd011991.pub2. PMC 8504433. PMID 27113367.
- 1 2 Fokkens W, Lund V, Mullol J (2007). "European position paper on rhinosinusitis and nasal polyps 2007". Rhinology. Supplement. 20 (1): 1–136. doi:10.1017/S0959774306000060. PMID 17844873. S2CID 35987497.
- ↑ Thomas M, Yawn BP, Price D, Lund V, Mullol J, Fokkens W (June 2008). "EPOS Primary Care Guidelines: European Position Paper on the Primary Care Diagnosis and Management of Rhinosinusitis and Nasal Polyps 2007 - a summary". Primary Care Respiratory Journal. 17 (2): 79–89. doi:10.3132/pcrj.2008.00029. PMC 6619880. PMID 18438594.
- ↑ Venekamp RP, Thompson MJ, Hayward G, Heneghan CJ, Del Mar CB, Perera R, et al. (March 2014). "Systemic corticosteroids for acute sinusitis" (PDF). The Cochrane Database of Systematic Reviews (3): CD008115. doi:10.1002/14651858.CD008115.pub3. PMC 11179165. PMID 24664368. Archived (PDF) from the original on 2019-11-15. Retrieved 2019-11-15.
- ↑ Head K, Chong LY, Hopkins C, Philpott C, Schilder AG, Burton MJ (April 2016). "Short-course oral steroids as an adjunct therapy for chronic rhinosinusitis". The Cochrane Database of Systematic Reviews. 2016 (4): CD011992. doi:10.1002/14651858.cd011992.pub2. PMC 8763342. PMID 27115214. S2CID 205210682.
- ↑ Meghanadh DK (2022-12-16). "Fungal sinusitis - causes, symptoms, and treatment". Medy Blog. Archived from the original on 2023-05-05. Retrieved 2023-05-05.
- ↑ Tichenor WS (2007-04-22). "FAQ — Sinusitis". Archived from the original on 2007-11-01. Retrieved 2007-10-28.
- ↑ Rimmer J, Fokkens W, Chong LY, Hopkins C (1 December 2014). "Surgical versus medical interventions for chronic rhinosinusitis with nasal polyps". The Cochrane Database of Systematic Reviews. 2014 (12): CD006991. doi:10.1002/14651858.CD006991.pub2. PMC 11193160. PMID 25437000.
- ↑ Sharma R, Lakhani R, Rimmer J, Hopkins C (November 2014). "Surgical interventions for chronic rhinosinusitis with nasal polyps". The Cochrane Database of Systematic Reviews. 2014 (11): CD006990. doi:10.1002/14651858.cd006990.pub2. PMC 11166467. PMID 25410644.
- ↑ Stammberger H (February 1986). "Endoscopic endonasal surgery--concepts in treatment of recurring rhinosinusitis. Part I. Anatomic and pathophysiologic considerations". Otolaryngology–Head and Neck Surgery. 94 (2): 143–7. doi:10.1177/019459988609400202. PMID 3083326. S2CID 34575985.
- 1 2 Meghanadh DK (2023-02-07). "Sinusitis Surgery: An Overview of the Different Technologies". Medy Blog. Archived from the original on 2023-05-05. Retrieved 2023-05-05.
- ↑ Liang J, Lane AP (March 2013). "Topical Drug Delivery for Chronic Rhinosinusitis". Current Otorhinolaryngology Reports. 1 (1): 51–60. doi:10.1007/s40136-012-0003-4. PMC 3603706. PMID 23525506.
- ↑ Takahara M, Kumai T, Kishibe K, Nagato T, Harabuchi Y (2021). "Extranodal NK/T-Cell Lymphoma, Nasal Type: Genetic, Biologic, and Clinical Aspects with a Central Focus on Epstein-Barr Virus Relation". Microorganisms. 9 (7): 1381. doi:10.3390/microorganisms9071381. PMC 8304202. PMID 34202088.
{{cite journal}}: CS1 maint: multiple names: authors list (link)
- "This article is an open access article distributed under the terms and conditions of the Creative Commons Attribution (CC BY) license (https://creativecommons.org/licenses/by/4.0/ Archived 2017-10-16 at the Wayback Machine)." - ↑ Althoff A, Bibliowicz M (2017). "Extranodal Natural Killer/T-Cell Lymphoma: An Incidental Finding". Cureus. 9 (5): e1260. doi:10.7759/cureus.1260. PMC 5476476. PMID 28652944.
- ↑ Anon JB (April 2010). "Upper respiratory infections". The American Journal of Medicine. 123 (4 Suppl): S16-25. doi:10.1016/j.amjmed.2010.02.003. PMID 20350632.
- ↑ Dykewicz MS, Hamilos DL (February 2010). "Rhinitis and sinusitis". The Journal of Allergy and Clinical Immunology. 125 (2 Suppl 2): S103-15. doi:10.1016/j.jaci.2009.12.989. PMID 20176255.
External links
- "Sinusitis". MedlinePlus. U.S. National Library of Medicine.